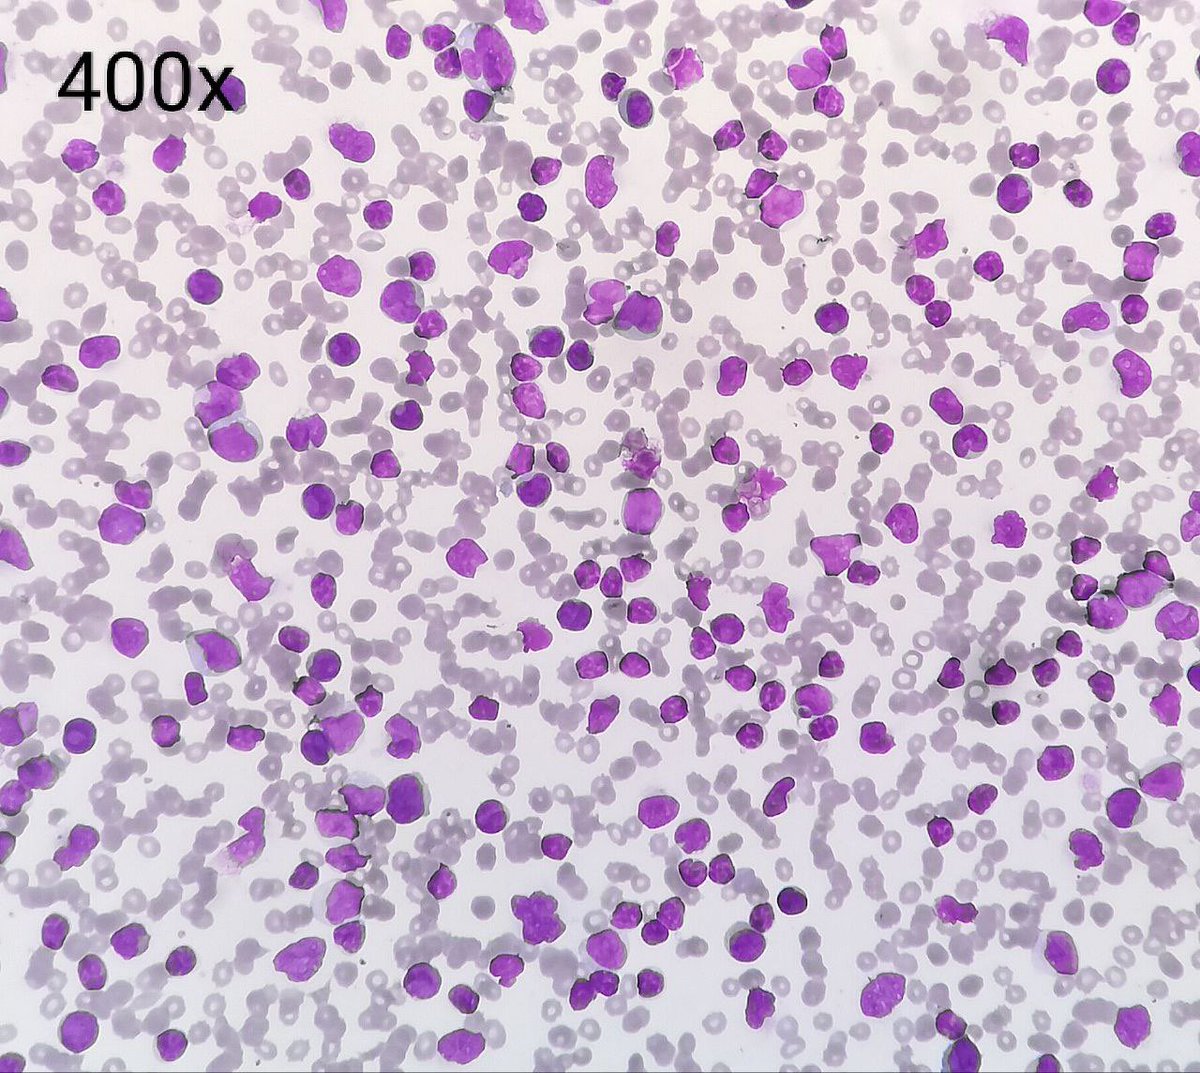
Thulas31081987's tweet image. When the bad and ugly stare at you together 😳
A case of concurrent Chronic Lymphocytic Leukemia and Acute Myeloid Leukemia 
#AML #CLL #Flowcytometry #FlowTCS2024
@ICCS_Education @drkunalsehgal @ananthvikas @DrArunCMC @LakshmiKoulmane @drdatari  @DrAnilHandoo @CytometryIndia

#flowcytometry 搜尋結果
This month’s publication spotlight, featured in “ACS Nano”, examines the inflammatory responses elicited by different types of mRNA/LPNs in muscle tissue and explores their implications for vaccine design and immunogenicity. Check it out: hubs.la/Q03Vsm5v0 #flowcytometry

Day#2 of 16th TCS Annual Conference & Workshop 2024 on "Unraveling New Horizons of Cytometry" was a blast! Today's hands-on sessions on #FlowCytometry were enlightening. Thrilled to be a part of this event by @CytometryIndia! Over to @ACTREC_TMC to take the #FlowTCS2024 forward!

In the latest episode of #FlowStars, Virginia Litwin from @ISAC_CYTO shares the inspiring story behind the formation of @CYTOwomen & how it addresses the unique challenges & opportunities for women in #FlowCytometry! 🌟 Listen now! → With @YorkBioimaging buff.ly/iUGV2h6
Happy Flow Friday! Let’s play a game of “Specter Spotter”! Let us know in the comments if you spotted Specter! #flowfriday #flowcytometry #halloween
When the bad and ugly stare at you together 😳 A case of concurrent Chronic Lymphocytic Leukemia and Acute Myeloid Leukemia #AML #CLL #Flowcytometry #FlowTCS2024 @ICCS_Education @drkunalsehgal @ananthvikas @DrArunCMC @LakshmiKoulmane @drdatari @DrAnilHandoo @CytometryIndia



Straightforward diagnosis of a granulomatous lymphadenitis - sarcoidosis (Sydney Category II): ▫️Syncitial collections of epithelioid and spindle nuclei histiocytes ▫️No necrosis ▫️Giant cells ▫️#CellBlock #FlowCytometry Ziehl-Neelsen #FNAFriday #CytoPath #HemePath #EBUSFNA #ROSE




No offense to all the #flowcytometry gurus out there, but I hope #AI replaces us soon. Btw how many rubber bands need to die to get smear reviews safely across town? This was 2 days worth 🤣 #heme #PathTwitter #MedTwitter

📣We're seeking a postdoc to join us @MRC-LMB to investigate neuroimmune interactomes in tumour & viral immunity. If you find fascinating & want to learn about #neuroscience & #immunology, tracing neurons, molecular biology & #flowcytometry, apply! 🧠🫁🔬 mrc.tal.net/vx/mobile-0/ap…

#flowcytometry Managers position, London: kcl.ac.uk/jobs/130988-te…
🔬 This Comment to a recent HemaSphere paper highlights that the ELN Scoring System shows high sensitivity (89%) and specificity (98%) in diagnosing #MDS and #CMML, validated across large cohorts. A promising step toward robust, routine flow cytometric diagnostics. #FlowCytometry…
International conference and workshop begins at School of Biotechnology JNU #flowcytometry #workshop #CellBiology #cell2cellinteraction


🗓️Have a look to the upcoming Flow Cytometry workshops at CIPF ⤵️ 🔗cipf.es/education-trai… #FlowCytometry #CIPF

Spectral flow cytometry loveliness being installed at the @MRC_WIMM. A @BDandCo S8. Can’t wait to see what we can do with it. 👏🥳#flowcytometry #spectral #science #flow #facs #imaging

For our #flowcytometry peeps, would you like to have a single fix/perm protocol that is optimised for everything? One that preserves fluorophores while allowing simultaneous TF and cytokine staining? How about 100-fold cheaper? You got it: …rentprotocols.onlinelibrary.wiley.com/doi/10.1002/cp…
Such a beautifully organized immunodeficiency workshop Thanks, @drumairb, for organizing such an amazing workshop with excellent hands-on experience #FlowCytometry #ScienceInMotion @IcmrNiih @icmrnirrch @PrashantTembha1 @drumairb

Talk on approach to T cell lymphomas by flow Cytometry and role of TRBC1 testing by @drkunalsehgal #Hematocon2024Nagpur #flowcytometry

Mr Swapnil Walke (BD Biosciences) was actively involved giving the participants an up close look at the setup and working of FACSDiscover, a cutting edge instrument which facilitates image enabled cell sorting. @CytometryIndia #FlowTCS2024 #FlowCytometry


If you work in a #FlowCytometry core facility, then now's the time to register for Flow Cytometry Facilities Meeting 2026 (Jan 6-7) - and keep up to date with all the latest issues within the Flow community. Register now: rms.org.uk/rms-event-cale…

This month’s publication spotlight, featured in “ACS Nano”, examines the inflammatory responses elicited by different types of mRNA/LPNs in muscle tissue and explores their implications for vaccine design and immunogenicity. Check it out: hubs.la/Q03Vsm5v0 #flowcytometry

Come and join us on this informative course, plenty of time for questions and to hone your #flowcytometry analysis skills!
Bookings are now *OPEN* for Virtual Flow Cytometry Data Analysis Course Spring 2026. Great interactive, virtual course suitable for anyone relatively new to flow cytometry or those keen to expand their experience with applications and specific analysis 🙂 Book now:…

Don’t miss out on your chance to win the new Cytek® Muse® Micro cell analyzer! Entries close tonight. Have you entered? hubs.la/Q03VshhC0 #flowcytometry #imaging #upgrade

Flow cytometry: from immunology to AI-driven analysis! Explore how spectral detection, standardization, and computational advances are shaping the future of cell analysis. Read the full review published in BioEssays: onlinelibrary.wiley.com/doi/10.1002/bi… #FlowCytometry @Cytometryman

Happy Flow Friday! Kick off the weekend by sharpening your cell sorting skills with this curated playlist, featuring valuable tips and expert insights to help you navigate the complexities of cell sorting with confidence. hubs.ly/Q03V4NpJ0 #flowcytometry #happysorting

Check out our latest on-demand webinar, “Utilizing Imaging Flow Cytometry To Empower Studies Of Erythropoiesis”. Watch now: hubs.la/Q03V4Rth0 #flowcytometry #immunology #webinar

🔬 The Virtual European Flow Core Meeting takes place 4–5 Dec 2025. A two-day online event focused on new technologies, operational challenges and shared learning across Flow Cytometry Core Facilities. 🔗f.mtr.cool/gureioodml #FlowCytometry #CoreFacilities @RoyalMicroSoc

Did you know? The Cytek® Guava® easyCyte™ flow cytometer can meet the needs of many different applications. Learn More: hubs.la/Q03V4Rvk0 #flowcytometry #lifesciences #cellanalysis
#newpaper ☀️☀️Welcome to read the paper by Ricardo Usategui-Martín et al. | High-Dimensional Immune Profiling of Human Retinal Detachment Samples Using Spectral #FlowCytometry: A #Protocol for Intraocular Immunotyping 👉mdpi.com/2409-9279/8/6/… #retinaldetachment #immunemarkers

Cytek is awarding a Cytek Northern Lights™ system to one lucky lab. Learn more about this opportunity: hubs.la/Q03V4HSg0 #flowcytometry #lifesciences #givingback

#flowcytometry Managers position, London: kcl.ac.uk/jobs/130988-te…
🔬 Many GPCRs internalize via clathrin and beta arrestin, shaping receptor availability and ligand effects. Traditional signaling assays often miss these trafficking events. 👉 Read more: na2.hubs.ly/H0294fH0 #GPCR #DrugDiscovery #FlowCytometry #Multispan

✅ Interactomics (LC-MS/MS) - Proteomics and Metabolomics Core ✅ FACS analysis - Imaging and Flow Cytometry Core ✅ Confocal microscopy - Imaging and Flow Cytometry Core Thank you for trusting us! #FlowCytometry #ConfocalMicroscopy #Imaging #NeuralCrestDevelopment #Embryology
How can the Cytek® Amnis® ImageStream® Mk II imaging flow cytometer power your research? Find out here: hubs.la/Q03SKsRL0 #flowcytometry #lifesciences #cellanalysis
Invest in your research like a pro! For a limited time, stock up on reagents and receive a complimentary one-year Cytek® Cloud Pro license for 2026. Learn more: hubs.la/Q03PPRJ10 #flowcytometry #biotechnology #lifesciences

Don’t waste precious samples! The Flowmi™ Cell Strainers quickly filter samples, giving you a perfect single-cell suspension every time.Less waste, cleaner data, better results. Order through your preferred scientific distributor. #FlowCytometry #cytometry #FACS #Labsolutions

This month’s publication spotlight, featured in “Nature Biomedical Engineering”, discusses the inflammatory response around implanted biomaterials to understand the cellular phenotypes and mechanisms driving inflammation. Check it out: hubs.la/Q03RYr1d0 #flowcytometry

Join us at the #ASCP2025 Annual Meeting in Atlanta! Our Practical Flow Cytometry to Evaluate Lymphoproliferative Disorders course on Tuesday offers hands-on learning and real-world insights. A must-attend for anyone in #FlowCytometry or #Hematopathology @mnhemepath

Do you like #flowcytometry? Our fellows spend 3+ months in the flow lab. Take a look at our fellowship - med.umn.edu/pathology/educ… #leusm #mmsm #PathTwitter #PathX #FlowEdu #path2path #pathmatch2026 @SamreenfatimaMD @AmyBeckman272 @ismailelbaz88 @CadePathologyMD @umnhemepath

Do you want to learn more about #flowcytometry as well as our amazing #Hemepath fellowship - join us on Tuesday in Atlanta for your workshop #lymsm #leusm #mmsm #PathTwitter #PathX #FlowEdu #path2path #pathmatch2026 @SamreenfatimaMD
Unlock the power of flow cytometry in diagnosing lymphoproliferative disorders! Join Me and @mnhemepath at #ASCP2025 Annual Meeting for Practical Flow Cytometry to Evaluate Lymphoproliferative Disorders of the Blood and Marrow. #ASCP25 #Pathology #Hemepath #ICCS

Day#2 of 16th TCS Annual Conference & Workshop 2024 on "Unraveling New Horizons of Cytometry" was a blast! Today's hands-on sessions on #FlowCytometry were enlightening. Thrilled to be a part of this event by @CytometryIndia! Over to @ACTREC_TMC to take the #FlowTCS2024 forward!

Wrapped up an inspiring Day#1 at the 16th TCS Annual Conference & Workshop 2024 on "Unraveling New Horizons of Cytometry"! Thrilled with the discussions on #FlowCytometry and excited for what’s next. 🌟 @CytometryIndia #FlowTCS2024

New beginnings - we are so thrilled that @SamreenfatimaMD has joined our faculty! #hemepath #flowcytometry #PathMatch

📣🔥5th Online International #FlowCytometry Course, 2nd - 4th September 2024 | Register Now helpbiotech.co.in/2024/08/5th-on… @FlowSols


🗓️Have a look to the upcoming Flow Cytometry workshops at CIPF ⤵️ 🔗cipf.es/education-trai… #FlowCytometry #CIPF

When the bad and ugly stare at you together 😳 A case of concurrent Chronic Lymphocytic Leukemia and Acute Myeloid Leukemia #AML #CLL #Flowcytometry #FlowTCS2024 @ICCS_Education @drkunalsehgal @ananthvikas @DrArunCMC @LakshmiKoulmane @drdatari @DrAnilHandoo @CytometryIndia

Talk on approach to T cell lymphomas by flow Cytometry and role of TRBC1 testing by @drkunalsehgal #Hematocon2024Nagpur #flowcytometry

You know you’re a flow geek when you get a flow cytometer for your birthday!! 🤣🌈❤️ @CytekBio #NorthernLights #flowcytometry @UWAresearch

If you work in a #FlowCytometry core facility, then now's the time to register for Flow Cytometry Facilities Meeting 2026 (Jan 6-7) - and keep up to date with all the latest issues within the Flow community. Register now: rms.org.uk/rms-event-cale…

Straightforward diagnosis of a granulomatous lymphadenitis - sarcoidosis (Sydney Category II): ▫️Syncitial collections of epithelioid and spindle nuclei histiocytes ▫️No necrosis ▫️Giant cells ▫️#CellBlock #FlowCytometry Ziehl-Neelsen #FNAFriday #CytoPath #HemePath #EBUSFNA #ROSE




🔬 Modulight ML6640 lasers power flow cytometry with up to 4 wavelengths (UV–638 nm), AI beam alignment, flat-top beams, and cloud-connected predictive maintenance. High flexibility for research & diagnostics! Learn more: modulight.com/applications/f… #FlowCytometry #Modulight



This month’s publication spotlight, featured in “ACS Nano”, examines the inflammatory responses elicited by different types of mRNA/LPNs in muscle tissue and explores their implications for vaccine design and immunogenicity. Check it out: hubs.la/Q03Vsm5v0 #flowcytometry

International conference and workshop begins at School of Biotechnology JNU #flowcytometry #workshop #CellBiology #cell2cellinteraction


Is your #microscopy or #FlowCytometry facility on the RMS Facilities Database? This is a great resource for imaging and flow facilities across the globe 😃🔬🌍 Find out more and add your facility details: ow.ly/khgn50Wuwg7

Mrs Debjani Kundu (Cytek Biosciences) demonstrated spectral #FlowCytometry and its capabilities in resolving complex fluorophore spectra. She told about its operation, emphasizing advantages of spectral unmixing and high-dimensional data acquisition. @CytometryIndia #FlowTCS2024


Akış Sitometri hakkında bir #bioinfonotes paylaşılmıştır. Bilimsel kısa bilgi notları içeren bir @bioinfocodes hesabımızı takip edebilirsiniz. #flowcytometry #cytometry #electomagnets #fluiddroplet #bilimlekalalım


The new BD FACSDiscover S8 is finally in-house at @DZNE_en SystemsMedicine department! 🤯 Serial number 009 - licensed to flow 😎Excited to put our hands on it! @BDBiosciences @LabSchultze #flowcytometry #spectralflow #cellview

Day#2 of 16th TCS Annual Conference & Workshop 2024 on starts with Dr Sushilkumar Ramdasi (Beckman Coulter) acquainting the participants with Cytobank, a cloud based analytical platform to manage and analyze multi dimensional #FlowCytometry data. @CytometryIndia #FlowTCS2024



Dr. Umair presents data on CVID workup and machine learning algorithms in #FlowCytometry #FlowTCS2024

Something went wrong.
Something went wrong.
United States Trends
- 1. Giannis 68.4K posts
- 2. #AEWDynamite 8,432 posts
- 3. Kevin Knight 1,128 posts
- 4. Kyle Fletcher N/A
- 5. #Survivor 1,451 posts
- 6. #iubb N/A
- 7. Spotify 1.71M posts
- 8. Bucks 42.5K posts
- 9. #AbbottElementary N/A
- 10. Steve Cropper 2,257 posts
- 11. #TheChallenge41 N/A
- 12. Eddie Kingston 1,114 posts
- 13. Milwaukee 18.4K posts
- 14. Tosin 66.6K posts
- 15. Mikel N/A
- 16. Brazile N/A
- 17. Andrews 10.1K posts
- 18. Leeds 104K posts
- 19. Samoa Joe 1,040 posts
- 20. Phantasm 2,043 posts















































